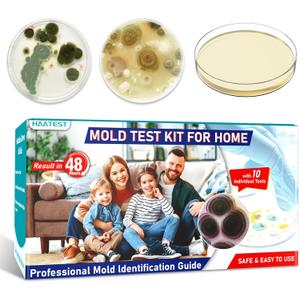

Hemoglobin Test Kit with 25 Hemoglobin Test Strips, Cholesterol Test Kit with 10 Test Strips, 2-in-1 Hemoglobin Test Meter at home, Hemoglobin Tester for Home Use, Complete Home Test Kit, Easy to Use.
Condition: New
Pickup Details
| Tuesday, Oct 14 | 12:00PM - 06:30PM |
| Wednesday, Oct 15 | 11:00AM - 06:30PM (Appointment only) |
| Thursday, Oct 16 | 08:00AM - 02:00PM |
| Friday, Oct 17 | 08:00AM - 02:00PM |
Product Details
| SKU | OLARR4647867 |
| ASIN | B0DSH6VVC4 |